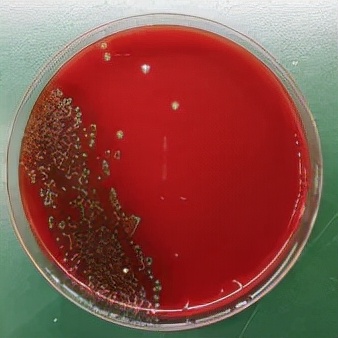
一隻基圍蝦引發的“血案”!常吃海鮮的人要注意 一隻基圍蝦引發的“血案”!常吃海鮮的人要注意
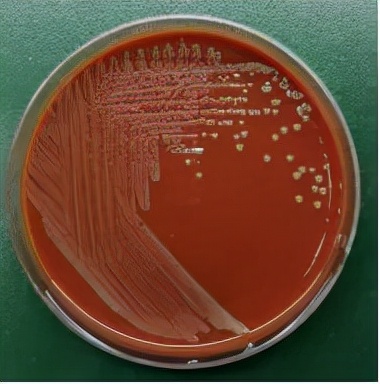
一隻基圍蝦引發的“血案”!常吃海鮮的人要注意 一隻基圍蝦引發的“血案”!常吃海鮮的人要注意

來源:溫州醫科大學附屬第一醫院
提到基圍蝦,你會想到什麼?
味道鮮美?營養豐富?
然而,對於19歲的小紅(化名)來說
估計在很長一段時間內都會有吃蝦的陰影了
在她身上究竟發生了什麼?
20多天前,小紅在家處理海鮮時,不小心被一隻基圍蝦刺破了右手手指的面板。對於很多人來說,這是再小不過的廚房插曲,傷口也只有一點點大,因此她就沒放在心上。然而,這個肉眼幾乎看不到的小傷口,居然逐漸發展為手指面板紅腫破潰,20多天都沒有癒合,嚴重影響了她的日常工作和生活。
苦惱之際,小紅來到溫醫大附一院燒傷科就診。經醫生檢查發現,小紅的右手第三指面板紅腫破潰,基底壞死伴肉芽組織增生,手指活動稍受限。透過詢問病史後得知,小紅20多天前曾被一隻基圍蝦刺破手指面板。罪魁禍首莫不就是這隻基圍蝦?!
為進一步明確病原體,醫生對小紅的傷口進行清創處理,然後取創面滲液立即送檢細菌培養,並採用藥物進行抗感染促愈治療。
沿海地區人們喜食海鮮,因為生吃海鮮或海鮮刺傷引起的感染屢見不鮮,這次又會是什麼病原菌呢?
醫學檢驗中心微生物室在收到創面滲液標本後,立即接種培養並塗片鏡檢。塗片經革蘭染色後,在顯微鏡下可以看見大量中性粒細胞,提示感染可能性大。可惜的是,直接鏡檢並沒有發現病原菌的蹤跡。創面滲液經24小時培養後,實驗室老師發現血平板上長出了細細小小的菌落,便趕緊挑取菌落進行塗片並染色,顯微鏡下可以清晰看到大量的革蘭陰性球杆菌。但具體屬於哪個菌種,常規的鑑定方法還無法鑑定。
考慮到可能是菌落生長不良的原因,為此,實驗室老師進一步延長了培養時間。當標本繼續培養至第4天時,可以觀察到平板上菌落稍長大了一些,呈圓形溼潤、灰白凸起的菌落,但常規的生化鑑定和質譜鑑定方法仍然未能鑑定出細菌種屬。
這一現象提醒大家,這種細菌應該不是臨床上常見的細菌!最後,透過16S rRNA測序比對,真相終於水落石出!原來,這是一種十分罕見的細菌——海岸嗜半胱氨酸菌。
經過查閱相關文獻資料,微生物室對該菌進行抗菌藥物敏感性檢測。根據藥敏試驗結果,醫生採用左氧氟沙星進行抗感染治療,經過一個多月的口服藥物治療,小紅手上的傷口逐漸好轉,最終治癒。
什麼是海岸嗜半胱氨酸菌?
海岸嗜半胱氨酸菌(Cysteiniphilum litorale)是一種革蘭陰性球杆菌,隸屬於硫發菌目的苛養桿菌科。該菌最初分離於中國珠海的外伶仃島海岸,因具有L-半胱氨酸的生長依賴性,故而命名,16S rRNA基因序列分析顯示,該菌與高致病性土拉弗朗西斯親緣關係較近。
經過文獻檢索與查新,該案例為首次發現海岸嗜半胱氨酸菌感染人類,相關論文發表於Indian Journal of Medical Microbiology。
該如何進行治療?
海岸嗜半胱氨酸菌產β-內醯胺酶,所以對β-內醯胺類抗生素(包括臨床常用的頭孢菌素類藥物等)天然耐藥。明確病原菌後,醫生會根據具體情況選用氯黴素、環丙沙星、多西環素、慶大黴素、左氧氟沙星及四環素等進行治療。
在這裡,建議大家在處理海鮮時應佩戴手套,避免被海鮮刺傷,
面板有創口未癒合時,要避免接觸海鮮、海水,
如果不小心被海鮮扎傷,應該第一時間將傷口處血液擠出,然後用清水沖洗,
如果面板出現紅腫、疼痛等症狀,建議及時至正規醫院就診。